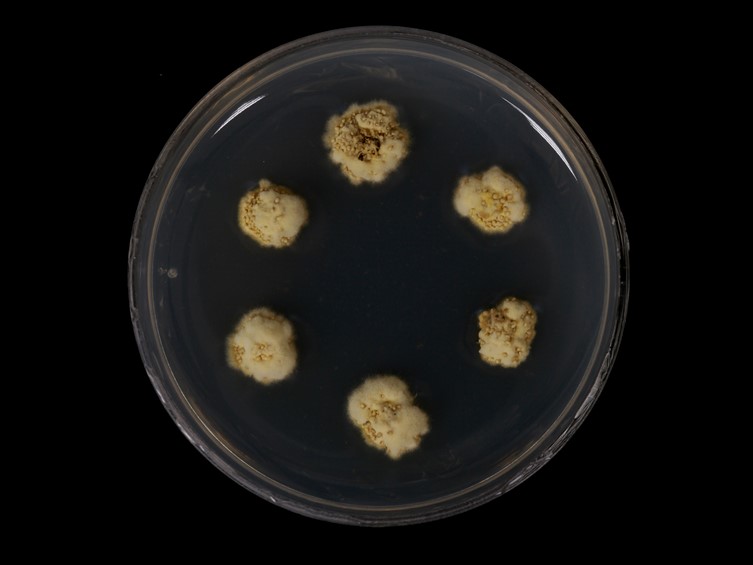

Holotype:
THAILAND, Ranong Province, Khlong Naka Wildlife Sanctuary, 12 Jan. 2006, L.T. Hung, S. Mongkolsamrit, P. Srikitikulchai, K. Tasanathai, B. Tongnuch, W. Tongsridam, holotype BBH 17373, ex-type living culture BCC 20635.
Habitat:
Underside of dicotyledonous leaves.
Host:
Scale insects (Hemiptera).
Description:
 Stroma pulvinate, oval or circular, consisting of dense interwoven hyphae, base constricted, spreading, forming a membranous hypothallus, up to 2.5 mm diam, 2 mm high, cream-brown when fresh.
Stroma pulvinate, oval or circular, consisting of dense interwoven hyphae, base constricted, spreading, forming a membranous hypothallus, up to 2.5 mm diam, 2 mm high, cream-brown when fresh.  Conidioma pycnidial usually single, embedded in the centre of the stroma, 350-400 μm high, 300-350 μm diam.
Conidioma pycnidial usually single, embedded in the centre of the stroma, 350-400 μm high, 300-350 μm diam.  Conidiogenous cells phialidic cylindrical, up to 20 μm long.
Conidiogenous cells phialidic cylindrical, up to 20 μm long.  Pycnidial paraphyses present, linear, filiform, flexuous, up to 150 μm long, 1.5 μm wide.
Pycnidial paraphyses present, linear, filiform, flexuous, up to 150 μm long, 1.5 μm wide.  Conidia fusoid, sometimes narrowly fusiform, with rounded ends, 5-6 × 1.2-1.5 μm.
Conidia fusoid, sometimes narrowly fusiform, with rounded ends, 5-6 × 1.2-1.5 μm.
Culture characteristics:
Colonies on PDA slow-growing, attaining 4–6 mm diam in 4 wk, with old cultures developing a pale brown pigment in PDA. Stromatic colonies pale brown, becoming darker when old, forming compact, wrinkled stromata. Conidial masses pale yellow, appearing as abundant slime masses from immersed pycnidia scattered over the surface.
Colonies on PDA slow-growing, attaining 4–6 mm diam in 4 wk, with old cultures developing a pale brown pigment in PDA. Stromatic colonies pale brown, becoming darker when old, forming compact, wrinkled stromata. Conidial masses pale yellow, appearing as abundant slime masses from immersed pycnidia scattered over the surface.
Other Available strains
TBRC-BCC 28712Reference:
Mongkolsamrit S, Luangsa-ard JJ, Spatafora JW, et al. (2009). A combined ITS rDNA and beta-tubulin phylogeny of Thai species of Hypocrella with non-fragmenting ascospores. Mycological Research 113: 684–699.
DOI: https://doi.org/10.1016/j.mycres.2009.02.004Species |
Strain |
Compound |
Pubchem CID |
Biological activity |
Reference |
|---|---|---|---|---|---|
| Aschersonia minutispora | TBRC-BCC 28712 | Sterigmatocystin (10): Aspergillus versicolor | 159931 | Antimicrobial acitvity against E. coli | Lee et al. 2010 |
| Aschersonia minutispora | TBRC-BCC 28712 | Sterigmatin (13): TEST | 159931 | Antimicrobial acitvity against S. aureus | Hamasaki et al. 1973 |
|
Strain |
ITS | β-tubulin |
|---|---|---|
| BCC 17847 | DQ365849 | - |
| BCC 20635 | EU409583 | EU409565 |
| BCC 7959 | DQ365836 | EU417560 |